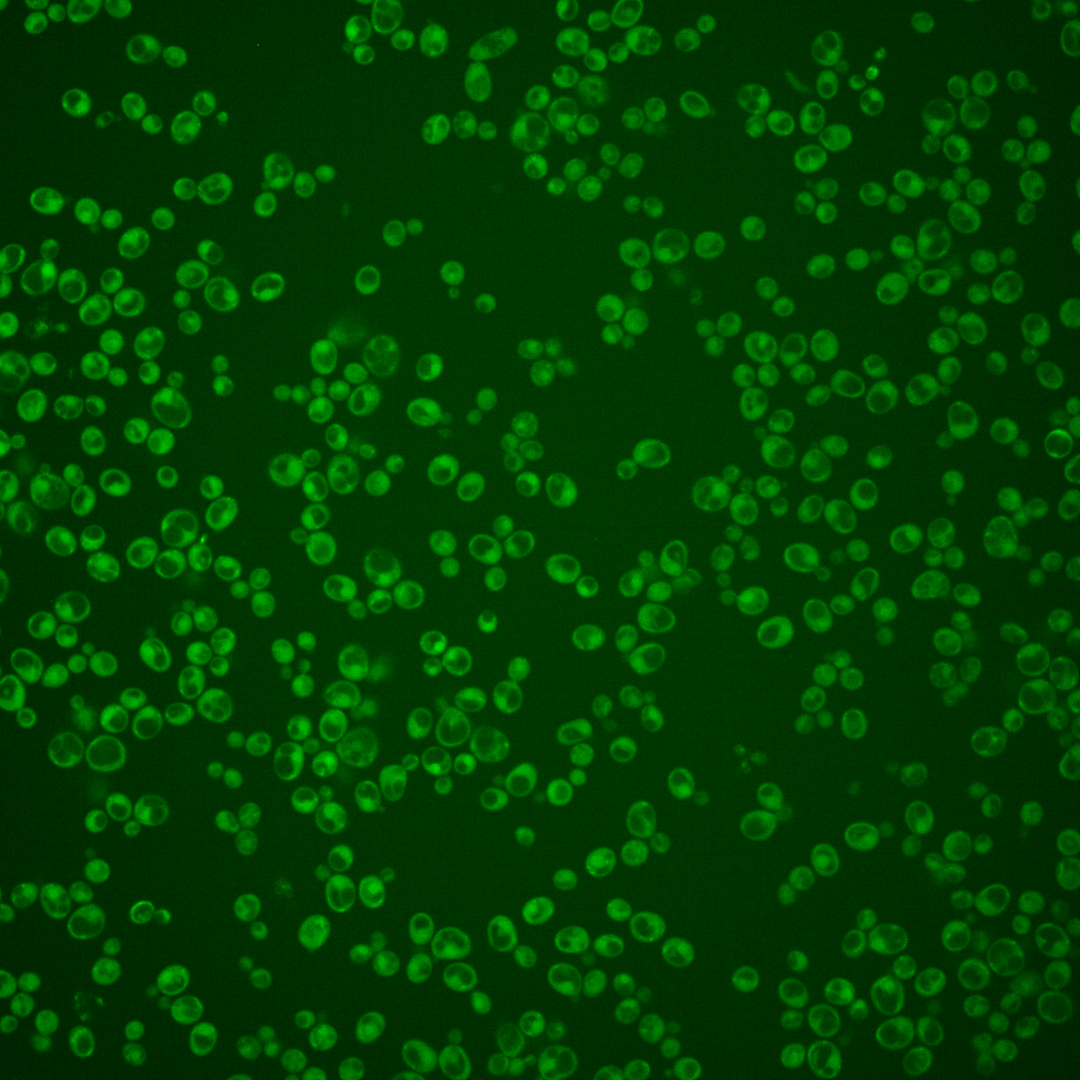
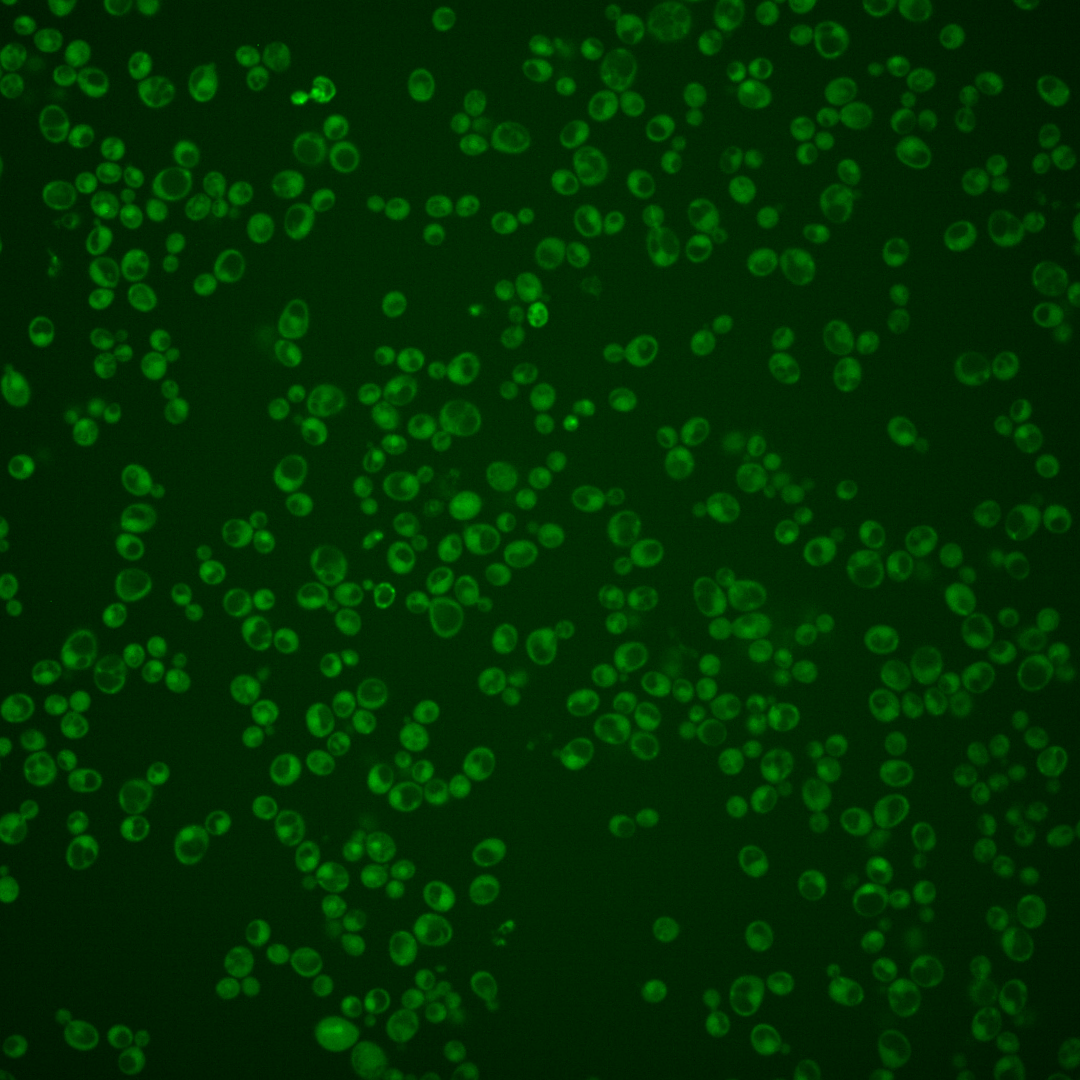
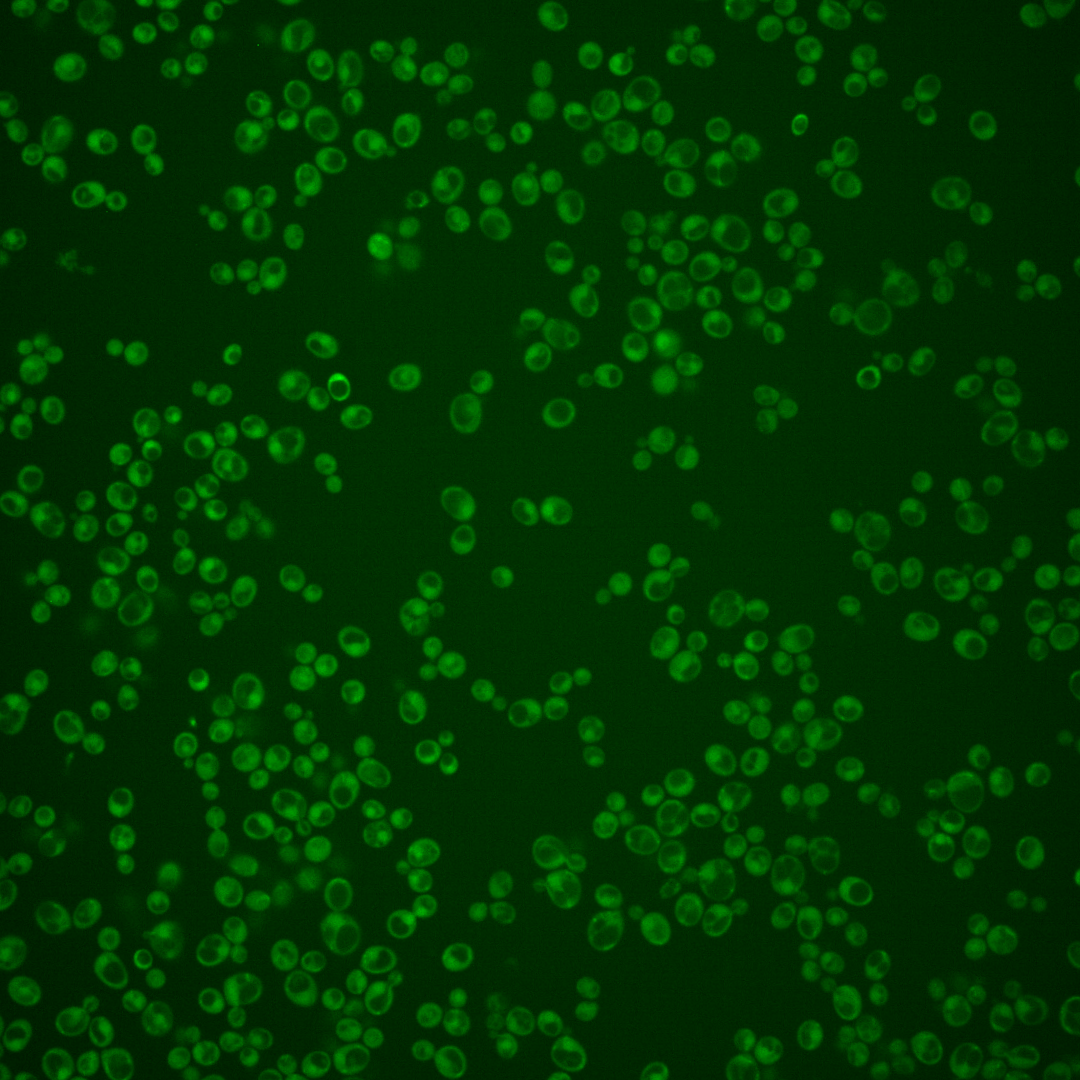
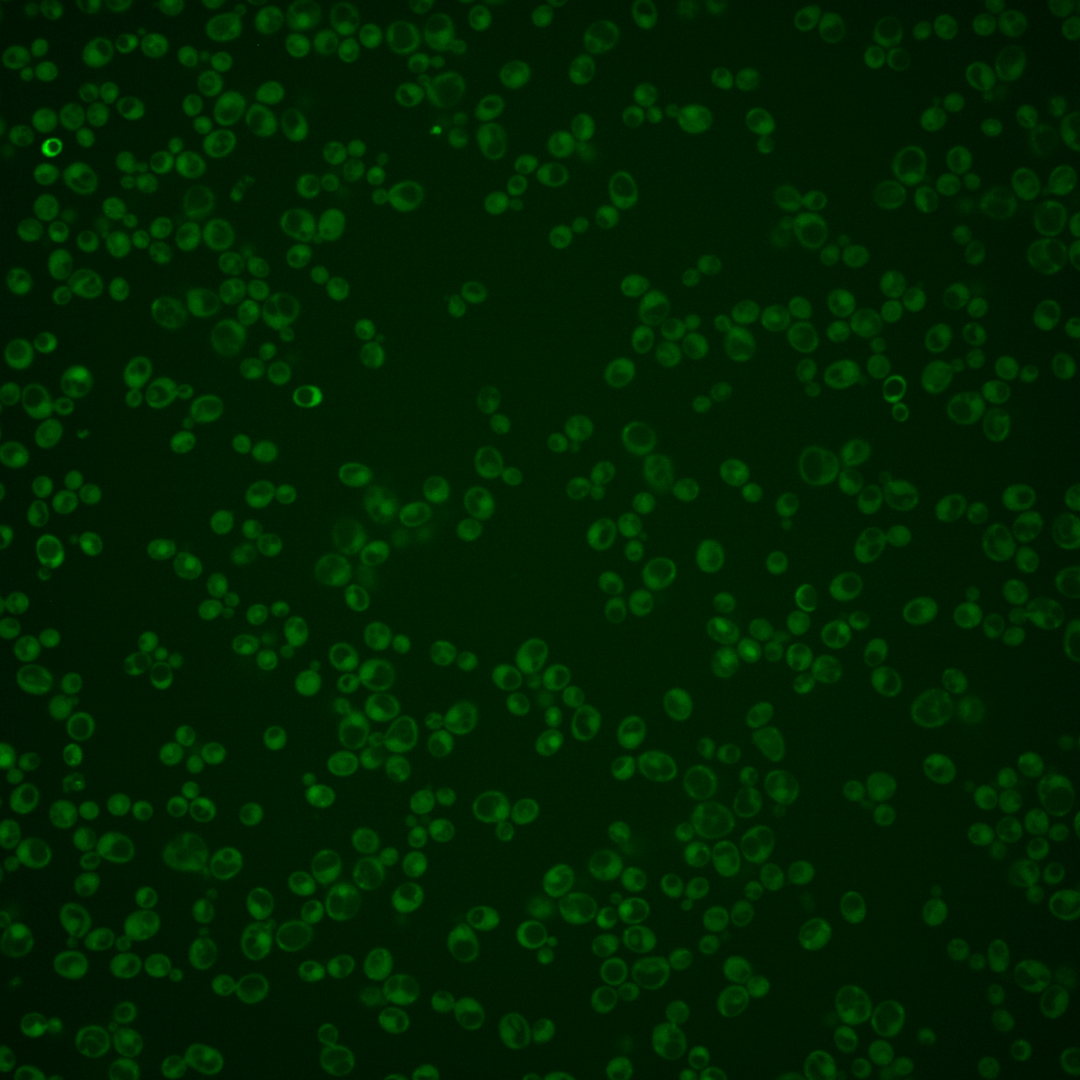
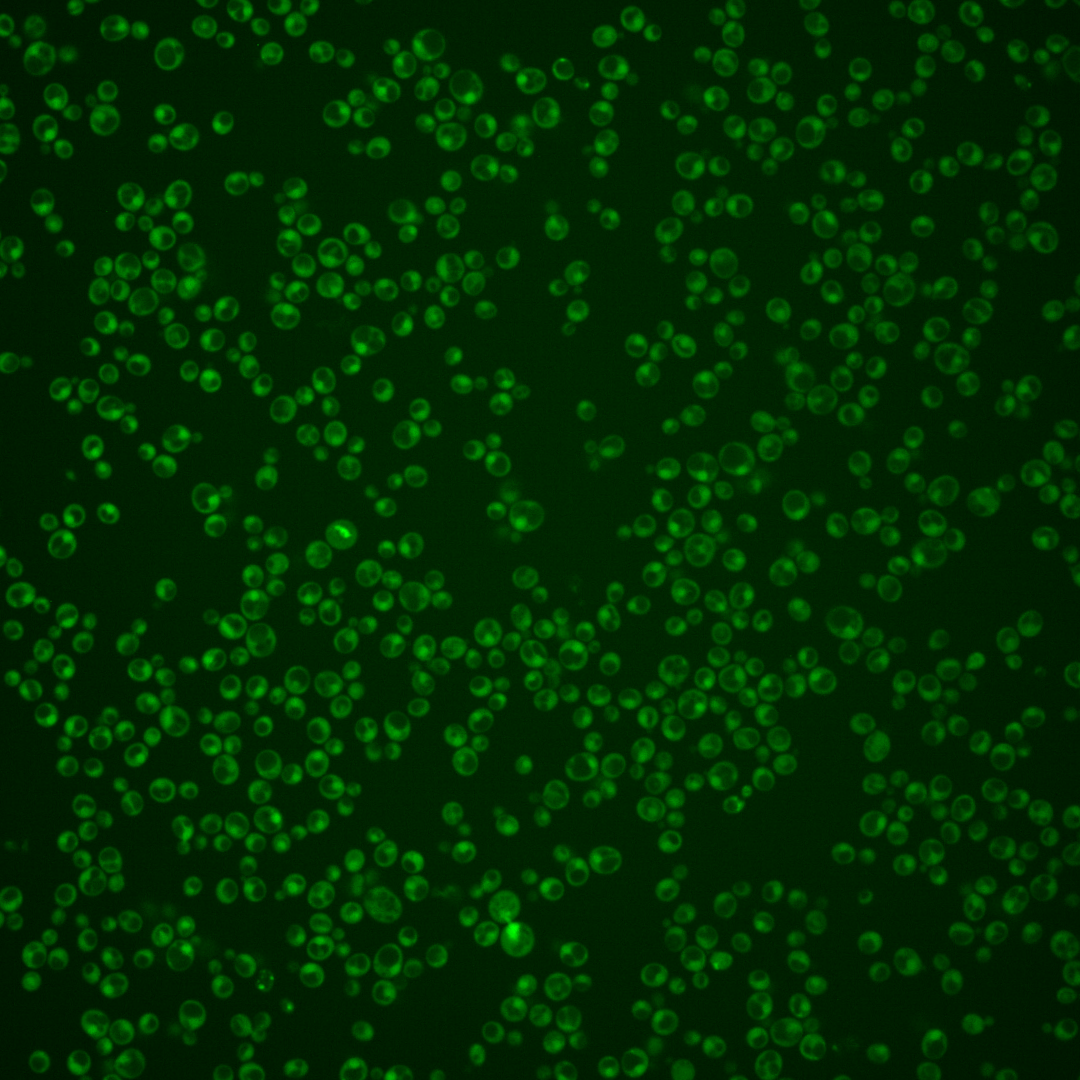
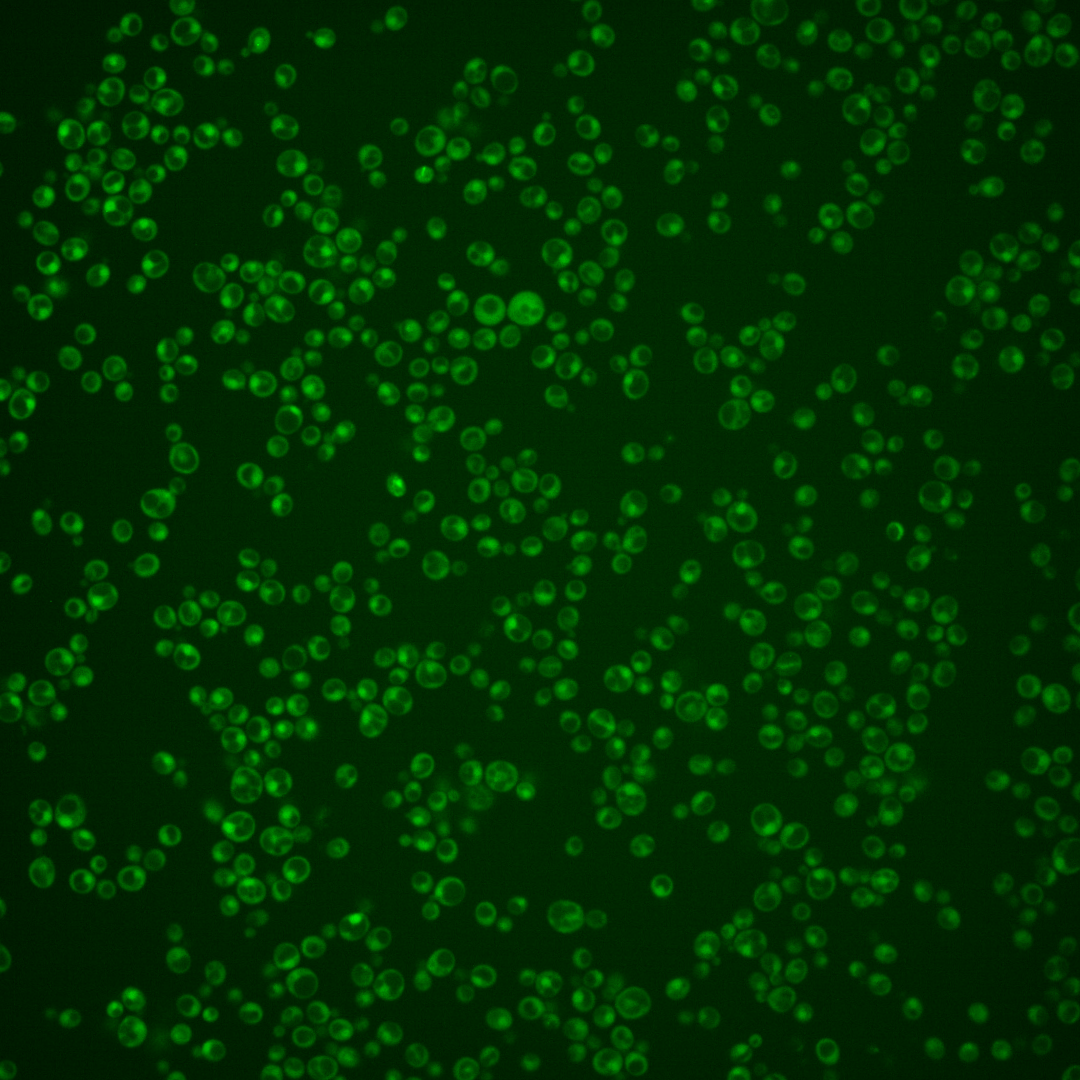

| Standard name | |
|---|---|
| Human Ortholog | |
| Description | mRNA 5'-end-capping quality-control protein; has distributive, 5'-3' exoRNase activity; similar to Rai1p; |
Micrographs




















































































Sub-cellular Localization
Yeast GFP Assignment
Protein Abundance
Localization Change
External localization resources
| ensLOC | DeepLoc | |||||||||||||||||||||||
|---|---|---|---|---|---|---|---|---|---|---|---|---|---|---|---|---|---|---|---|---|---|---|---|---|
| Localization | WT1 | WT2 | WT3 | RAP60 | RAP140 | RAP220 | RAP300 | RAP380 | RAP460 | RAP540 | RAP620 | RAP700 | HU80 | HU120 | HU160 | rpd3Δ_1 | rpd3Δ_2 | rpd3Δ_3 | WT1 | WT2 | WT3 | AF100 | AF140 | AF180 |
| Cortical Patches | 0 | 0 | 0 | 0 | 0 | 0 | 0 | 0 | 0 | 0 | 0 | 0 | 0 | 0 | 0 | 0 | 0 | 0 | 0 | 1 | 4 | 1 | 1 | 4 |
| Bud | 0 | 0 | 0 | 0 | 2 | 12 | 12 | 15 | 14 | 4 | 22 | 18 | 0 | 0 | 0 | 0 | 1 | 0 | 0 | 0 | 2 | 3 | 7 | 5 |
| Bud Neck | 0 | 0 | 1 | 0 | 0 | 3 | 6 | 6 | 1 | 4 | 3 | 6 | 2 | 1 | 0 | 1 | 1 | 0 | 0 | 0 | 0 | 1 | 1 | 2 |
| Bud Site | 0 | 0 | 0 | 0 | 0 | 0 | 0 | 2 | 0 | 1 | 4 | 2 | 0 | 0 | 0 | 0 | 0 | 0 | – | – | – | – | – | – |
| Cell Periphery | 0 | 0 | 1 | 0 | 2 | 1 | 2 | 6 | 1 | 3 | 1 | 1 | 0 | 0 | 5 | 1 | 2 | 4 | 0 | 0 | 1 | 0 | 1 | 2 |
| Cytoplasm | 17 | 102 | 254 | 228 | 354 | 391 | 501 | 518 | 301 | 321 | 225 | 314 | 276 | 303 | 469 | 172 | 130 | 100 | 41 | 102 | 216 | 167 | 243 | 232 |
| Endoplasmic Reticulum | 0 | 2 | 0 | 0 | 0 | 1 | 1 | 1 | 0 | 0 | 1 | 3 | 1 | 2 | 3 | 12 | 8 | 7 | 0 | 0 | 0 | 3 | 2 | 5 |
| Endosome | 0 | 0 | 0 | 0 | 0 | 0 | 0 | 2 | 0 | 0 | 0 | 0 | 2 | 2 | 1 | 2 | 2 | 0 | 0 | 1 | 3 | 2 | 1 | 3 |
| Golgi | 0 | 0 | 0 | 0 | 0 | 0 | 0 | 0 | 0 | 0 | 0 | 0 | 0 | 0 | 0 | 0 | 0 | 0 | 0 | 0 | 0 | 0 | 0 | 0 |
| Mitochondria | 1 | 2 | 24 | 29 | 52 | 172 | 275 | 272 | 215 | 220 | 185 | 251 | 0 | 0 | 0 | 16 | 8 | 4 | 3 | 4 | 16 | 9 | 15 | 27 |
| Nucleus | 0 | 0 | 0 | 1 | 1 | 2 | 0 | 6 | 3 | 2 | 3 | 2 | 1 | 0 | 0 | 2 | 0 | 0 | 0 | 0 | 0 | 1 | 1 | 0 |
| Nuclear Periphery | 0 | 1 | 0 | 0 | 0 | 1 | 0 | 0 | 0 | 1 | 0 | 0 | 0 | 0 | 0 | 0 | 0 | 1 | 0 | 0 | 0 | 0 | 0 | 0 |
| Nucleolus | 0 | 0 | 0 | 1 | 1 | 1 | 2 | 4 | 2 | 2 | 1 | 1 | 0 | 1 | 0 | 0 | 1 | 1 | 0 | 0 | 0 | 0 | 2 | 0 |
| Peroxisomes | 0 | 0 | 0 | 0 | 1 | 0 | 0 | 2 | 1 | 0 | 0 | 0 | 0 | 1 | 0 | 1 | 0 | 0 | 0 | 0 | 0 | 0 | 0 | 0 |
| SpindlePole | 0 | 0 | 1 | 1 | 2 | 5 | 6 | 5 | 6 | 11 | 8 | 9 | 0 | 0 | 1 | 0 | 3 | 0 | 2 | 0 | 3 | 2 | 2 | 2 |
| Vac/Vac Membrane | 0 | 0 | 0 | 1 | 1 | 1 | 2 | 1 | 4 | 1 | 0 | 3 | 2 | 1 | 2 | 2 | 0 | 2 | 0 | 0 | 2 | 5 | 10 | 15 |
| Unique Cell Count | 17 | 106 | 263 | 232 | 367 | 453 | 631 | 672 | 406 | 443 | 339 | 464 | 282 | 308 | 474 | 180 | 137 | 106 | 49 | 113 | 257 | 205 | 301 | 310 |
| Labelled Cell Count | 18 | 107 | 281 | 261 | 416 | 590 | 807 | 840 | 548 | 570 | 453 | 610 | 284 | 311 | 481 | 209 | 156 | 119 | 49 | 113 | 257 | 205 | 301 | 310 |
Yeast GFP Assignment
Protein Abundance
| Screen | WT1 | WT2 | WT3 | RAP60 | RAP140 | RAP220 | RAP300 | RAP380 | RAP460 | RAP540 | RAP620 | RAP700 | HU80 | HU120 | HU160 | rpd3Δ_1 | rpd3Δ_2 | rpd3Δ_3 | AF100 | AF140 | AF180 |
|---|---|---|---|---|---|---|---|---|---|---|---|---|---|---|---|---|---|---|---|---|---|
| Mean Cell GFP Intensity (1e-4) | 4.1 | 4.3 | 3.5 | 3.4 | 3.5 | 3.2 | 2.6 | 3.0 | 2.7 | 2.8 | 2.7 | 2.8 | 5.4 | 5.4 | 5.4 | 5.0 | 5.1 | 5.2 | 6.1 | 6.1 | 5.9 |
| Std Deviation (1e-4) | 0.3 | 0.7 | 0.8 | 1.2 | 1.5 | 1.2 | 1.1 | 1.4 | 1.3 | 1.4 | 1.2 | 1.4 | 1.4 | 1.8 | 1.6 | 1.4 | 1.1 | 1.3 | 2.3 | 2.1 | 1.8 |
| Intensity Change (Log2) | – | – | – | -0.02 | 0.01 | -0.1 | -0.39 | -0.22 | -0.34 | -0.32 | -0.35 | -0.31 | 0.64 | 0.63 | 0.64 | 0.53 | 0.55 | 0.58 | 0.83 | 0.81 | 0.77 |
Localization Change
| Localization | RAP60 | RAP140 | RAP220 | RAP300 | RAP380 | RAP460 | RAP540 | RAP620 | RAP700 | HU80 | HU120 | HU160 | rpd3Δ_1 | rpd3Δ_2 | rpd3Δ_3 |
|---|---|---|---|---|---|---|---|---|---|---|---|---|---|---|---|
| Actin | – | – | – | – | – | – | – | – | – | – | – | – | – | – | – |
| Bud | – | – | – | – | – | – | – | – | – | – | – | – | – | – | – |
| Bud Neck | – | – | – | – | – | – | – | – | – | – | – | – | – | – | – |
| Bud Site | – | – | – | – | – | – | – | – | – | – | – | – | – | – | – |
| Cell Periphery | – | – | – | – | – | – | – | – | – | – | – | – | – | – | – |
| Cyto | – | – | – | – | – | – | – | – | – | – | – | – | – | – | – |
| Endoplasmic Reticulum | – | – | – | – | – | – | – | – | – | – | – | – | – | – | – |
| Endosome | – | – | – | – | – | – | – | – | – | – | – | – | – | – | – |
| Golgi | – | – | – | – | – | – | – | – | – | – | – | – | – | – | – |
| Mitochondria | – | – | – | – | – | – | – | – | – | – | – | – | – | – | – |
| Nuclear Periphery | – | – | – | – | – | – | – | – | – | – | – | – | – | – | – |
| Nuc | – | – | – | – | – | – | – | – | – | – | – | – | – | – | – |
| Nucleolus | – | – | – | – | – | – | – | – | – | – | – | – | – | – | – |
| Peroxisomes | – | – | – | – | – | – | – | – | – | – | – | – | – | – | – |
| SpindlePole | – | – | – | – | – | – | – | – | – | – | – | – | – | – | – |
| Vac | – | – | – | – | – | – | – | – | – | – | – | – | – | – | – |
External localization resources
Images






























Protein Concentration and Protein Localization Data
| R1 | R2 | R3 | ||||||||||||||||
|---|---|---|---|---|---|---|---|---|---|---|---|---|---|---|---|---|---|---|
| G1 Pre-START | G1 Post-START | S/G2 | Metaphase | Anaphase | Telophase | G1 Pre-START | G1 Post-START | S/G2 | Metaphase | Anaphase | Telophase | G1 Pre-START | G1 Post-START | S/G2 | Metaphase | Anaphase | Telophase | |
| Concentration | – | – | – | – | – | – | – | – | – | – | – | – | – | – | – | – | – | – |
| Actin | 0.0008 | 0.0004 | 0.0012 | 0.0006 | 0.0005 | 0.0003 | 0.0145 | 0.0011 | 0.0013 | 0.0013 | 0.014 | 0.0036 | 0.0035 | 0.0001 | 0.0002 | 0.002 | 0 | 0.0872 |
| Bud | 0.0064 | 0.0082 | 0.0072 | 0.0095 | 0.0001 | 0.0072 | 0.0011 | 0.0009 | 0.0007 | 0.0002 | 0.0009 | 0.0003 | 0.0001 | 0.0002 | 0 | 0.0002 | 0 | 0.0005 |
| Bud Neck | 0.0003 | 0.0003 | 0.0003 | 0.0008 | 0.0003 | 0.0008 | 0.012 | 0.0001 | 0.0002 | 0.0002 | 0.0003 | 0.0005 | 0.0003 | 0 | 0 | 0.0005 | 0 | 0.0006 |
| Bud Periphery | 0.0026 | 0.0018 | 0.0022 | 0.0064 | 0.0001 | 0.0022 | 0.0027 | 0.0012 | 0.0016 | 0.0002 | 0.0017 | 0.0005 | 0.0002 | 0.0001 | 0 | 0.0002 | 0 | 0.0004 |
| Bud Site | 0.0063 | 0.0065 | 0.0069 | 0.0167 | 0.0001 | 0.0003 | 0.0039 | 0.0021 | 0.0041 | 0.0001 | 0.0013 | 0.0004 | 0.0009 | 0.0002 | 0.0001 | 0.0006 | 0 | 0.0007 |
| Cell Periphery | 0.0004 | 0.0004 | 0.0003 | 0.0003 | 0.0001 | 0.0002 | 0.0005 | 0.0005 | 0.0017 | 0.0003 | 0.0001 | 0.0001 | 0.0005 | 0.0001 | 0.0001 | 0.0003 | 0 | 0.0001 |
| Cytoplasm | 0.15 | 0.2037 | 0.2024 | 0.1646 | 0.2989 | 0.2431 | 0.1848 | 0.3389 | 0.2573 | 0.3773 | 0.3276 | 0.2325 | 0.2172 | 0.3573 | 0.4735 | 0.3119 | 0.0336 | 0.1799 |
| Cytoplasmic Foci | 0.0116 | 0.01 | 0.0133 | 0.0181 | 0.008 | 0.0091 | 0.0184 | 0.0145 | 0.01 | 0.0108 | 0.0127 | 0.0095 | 0.0142 | 0.0023 | 0.0037 | 0.052 | 0.0004 | 0.0309 |
| Eisosomes | 0.0003 | 0.0002 | 0.0002 | 0.0001 | 0.0014 | 0 | 0.0006 | 0.0001 | 0.0008 | 0.0001 | 0.0002 | 0.0001 | 0.0027 | 0 | 0 | 0.0001 | 0 | 0.0001 |
| Endoplasmic Reticulum | 0.0014 | 0.0009 | 0.0009 | 0.0007 | 0.001 | 0.0006 | 0.004 | 0.0028 | 0.0015 | 0.0013 | 0.0012 | 0.0014 | 0.0135 | 0.0008 | 0.0013 | 0.0315 | 0.0001 | 0.0013 |
| Endosome | 0.0021 | 0.0035 | 0.005 | 0.0036 | 0.0048 | 0.002 | 0.0125 | 0.0108 | 0.0061 | 0.0041 | 0.0131 | 0.0086 | 0.0075 | 0.0005 | 0.0009 | 0.1803 | 0 | 0.0626 |
| Golgi | 0.0003 | 0.0004 | 0.0004 | 0.0002 | 0.0003 | 0.0001 | 0.0051 | 0.0012 | 0.001 | 0.0004 | 0.0112 | 0.0027 | 0.0029 | 0.0001 | 0.0001 | 0.0098 | 0 | 0.0259 |
| Lipid Particles | 0.0008 | 0.0002 | 0.0001 | 0.0006 | 0.0001 | 0.0001 | 0.0049 | 0.0008 | 0.0026 | 0.0001 | 0.0114 | 0.0005 | 0.0452 | 0 | 0.0001 | 0.0233 | 0 | 0.0014 |
| Mitochondria | 0.0027 | 0.0009 | 0.0012 | 0.0006 | 0.0006 | 0.0005 | 0.0041 | 0.0012 | 0.0017 | 0.0003 | 0.0253 | 0.0021 | 0.031 | 0.0001 | 0.0001 | 0.0073 | 0 | 0.0095 |
| None | 0.8031 | 0.7534 | 0.7472 | 0.7397 | 0.6807 | 0.7272 | 0.7107 | 0.6177 | 0.7016 | 0.5993 | 0.5607 | 0.7329 | 0.6184 | 0.6373 | 0.5179 | 0.3488 | 0.9657 | 0.5873 |
| Nuclear Periphery | 0.0004 | 0.0007 | 0.0004 | 0.0013 | 0.0003 | 0.0004 | 0.0021 | 0.001 | 0.0008 | 0.0003 | 0.0011 | 0.0008 | 0.0009 | 0.0002 | 0.0003 | 0.0076 | 0 | 0.0004 |
| Nucleolus | 0.0017 | 0.0007 | 0.0006 | 0.0023 | 0.0001 | 0.0002 | 0.001 | 0.0002 | 0.0004 | 0.0001 | 0.0003 | 0.0001 | 0.0007 | 0 | 0 | 0.0011 | 0 | 0 |
| Nucleus | 0.0028 | 0.0041 | 0.0026 | 0.0093 | 0.001 | 0.0024 | 0.0016 | 0.001 | 0.0012 | 0.0006 | 0.0008 | 0.0007 | 0.0006 | 0.0002 | 0.0003 | 0.0036 | 0 | 0.0002 |
| Peroxisomes | 0.0003 | 0.0002 | 0.004 | 0.0007 | 0.0002 | 0.0002 | 0.0073 | 0.0002 | 0.0022 | 0.0001 | 0.0119 | 0.0005 | 0.0369 | 0 | 0 | 0.0026 | 0 | 0.0065 |
| Punctate Nuclear | 0.0039 | 0.0016 | 0.0027 | 0.0217 | 0.0003 | 0.0019 | 0.0018 | 0.0004 | 0.001 | 0.0003 | 0.0014 | 0.0004 | 0.0006 | 0.0001 | 0.0001 | 0.0055 | 0 | 0.0002 |
| Vacuole | 0.0015 | 0.0017 | 0.001 | 0.002 | 0.001 | 0.0008 | 0.0053 | 0.0028 | 0.002 | 0.0022 | 0.0019 | 0.0013 | 0.0019 | 0.0004 | 0.0011 | 0.008 | 0 | 0.0032 |
| Vacuole Periphery | 0.0002 | 0.0003 | 0.0002 | 0.0003 | 0.0002 | 0.0001 | 0.0012 | 0.0005 | 0.0003 | 0.0003 | 0.001 | 0.0003 | 0.0003 | 0 | 0.0001 | 0.0029 | 0 | 0.0011 |
Sequencing Data
| R1 | R2 | |||||||||
|---|---|---|---|---|---|---|---|---|---|---|
| G1 Post-START | S/G2 | Metaphase | Anaphase | Telophase | G1 Post-START | S/G2 | Metaphase | Anaphase | Telophase | |
| Gene Expression | 18.2655 | 13.3595 | 14.87 | 17.5288 | 17.7615 | 6.6383 | 16.3219 | 16.461 | 14.1446 | 17.9651 |
| Translational Efficiency | 0.6581 | 0.6105 | 0.6095 | 0.461 | 0.4963 | 1.3307 | 0.4962 | 0.5159 | 0.543 | 0.636 |
Hit Data
| Dataset | Hit |
|---|---|
| Protein Concentration | – |
| Protein Localization | ✘ |
| Gene Expression | ✘ |
| Translational Efficiency | ✘ |
Endocytosis
| Temp | Actin Patch (Sac6-tdTomato) | Cortical Patch (Sla1-GFP) | Late Endosome (Snf7-GFP) | Vacuole (Vph1-GFP) |
|---|---|---|---|---|
| 37℃ | ||||
| RT |
Cell Cycle Omics
CYCLoPs (Dxo1-GFP)
| Gene / Allele | Actin Patch (Sac6-tdTomato) | Cortical Patch (Sla1-GFP) | Late Endosome (Snf7-GFP) | Vacuole (Sac6-tdTomato) |
|---|
| Gene | Images |
|---|
| Gene | Images |
|---|
Images are not yet available
Images are not yet available